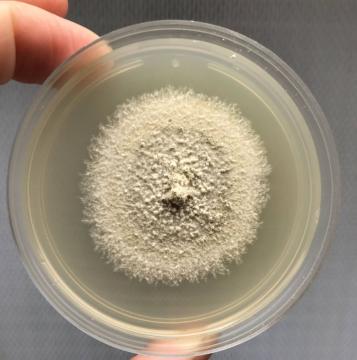
Fungal_culture.jpg

Research
Healthy, diverse, natural and agricultural environments are essential to ensure healthy lives and to promote well-being.
We focus on protection, restoration, and sustainable use of terrestrial ecosystems, to halt land degradation and biodiversity loss. This work is primality done within Mediterranean-type ecosystems (local and abroad), in wetlands and river systems. Work has also occurred in Afromontane forest and grassland systems, in remnant Miombo woodlands, in arid systems, and in the savanna.
Wildlife Management is the science and practice of managing wild animal populations and their habitats to achieve ecological, economic, and social objectives. It seeks to balance the needs of wildlife with those of humans while maintaining healthy ecosystems.
My team and I focus on the ecology of various large mammals, in particular predators, in both protected & non-protected areas throughout southern Africa. The aim of our research is not only to better understand the ecology of various wildlife species but also to provide management recommendations to landowners, farmers, government bodies, NGO’s, etc.
Parasites and parasitism represent more than 50% of biodiversity on earth. They keep host populations healthy.
We study the diversity, distribution and ecology of parasites associated with wildlife and especially rodents in South and southern Africa. This is relevant to the fields of biodiversity, disease ecology, wildlife management, food security and human health.
No life exists in isolation. Life did not take over the globe by combat, but by networking.
We study interactions between plants, insects and microbes. We are interested in the type of interactions (commensalism, antagonism, mutualism), their relational importance and the consequences if these interactions are disrupted. This is relevant to the fields of invasion biology, biocontrol, molecular ecology, reproductive biology and biodiversity.
Pests compete with humans for food. It is critical to keep the agroecosystem in balance as much as possible to avoid pest outbreaks.
Integrated Pest Management (IPM) is the use of all available management options, including biological, cultural, physical, semiochemicals, resistance, DNA technology, Sterile Insect Technique and chemicals (as a last resort) to control pest populations.
The aim is pest suppression, to below economically acceptable levels.
IPM is based on monitoring systems to estimate pest densities, which in turn determine the need for control. IPM should be practiced on an area-wide basis to be most effective, thereby incorporating the entire landscape, not just the crop or farm. Encouraging biodiversity, therefore, supports a more resilient agroecosystem.
We use physiological principles to develop a mechanistic understanding of insect biology and their life-cycles. We study diverse insect species in equally diverse settings (Antarctica to Kenya).
We integrate trait-based approaches, e.g. physiological and genetic information about the organism, coupled with environmental information (e.g. temperature, rainfall) to develop dynamic risk maps for climate change impacts and inform diverse stakeholders. Our research has applications in invasion biology, pest management, sustainable agriculture and forecasting climate change impacts.
Landscape ecology aims to conserve natural connectivity and natural structure, especially in modified ecosystems, such as urban and agricultural landscapes.
This field considers the spatial arrangement and interaction of patches across landscapes and describe biodiversity patterns and process across landscape mosaics that have natural, urban, agricultural and forestry elements across multiple scales.
Insects are the most diverse animal group, and support many ecological systems, including those on which humans depend. Yet insects are in decline due to land use transformation, climate change, pollution, and multiple other pressures.
The conservation of insects considers natural and anthropogenic environments, despite enormous gaps in knowledge and many uncertainties over the consequences of their loss. Insect conservation is a rapidly growing field, spanning ecology, taxonomy, molecular barcoding, remote sensing, and policy.
Agroecology, which is the holistic approach in which integration of ecological, economic, and social concepts to design and manage sustainable agriculture and forestry systems. Agroecology promotes natural processes to enhance ecosystem services, biodiversity, soil health and water quality, creating resilient and sustainable agricultural systems. This in turn provides long-term food security while encouraging biodiversity and regenerating farmland.
We can future-proof agriculture and forestry through living and dynamic landscapes.